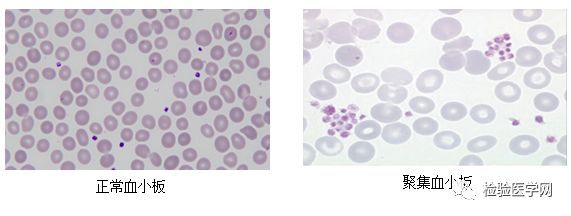

血小板计数的临床意义
血小板计数的概念
是指计数单位容积血液中血小板的数量,血小板计数的正常值为125~320×10^9/L。血小板减少是引起出血时间延长,严重损伤或在激状态可发生出血。当血小板计数<50×10^9/L时,轻度损伤可引起皮肤粘膜紫癜,手术后可能出血;当血小板计数<20×10^9/L时,常有自发性出血。
一般认为,当血小板计数<20×10^9/L时,需要预防性输入血小板。如果血小板计数>50×10^9/L,且血小板功能正常,则手术过程不至于出现明显出血。
1.血小板增多:当血小板计数大于400×10^9/L时即为血小板增多,原发性血小板增多常见于骨髓增生性疾病,如慢性粒细胞白血病,真性红细胞增多症,原发性血小板增多症等;血小板增多症常见于急慢性炎症,缺铁性贫血及癌症患者,此类增多一般不超过500×10^9/L,经治疗后情况改善,血小板数目会很快下降至正常水平。脾切除术后血小板会有明显升高,常高于600×10^9/L,随后会缓慢下降到正常范围。
2.血小板减少:当血小板计数小于100×10^9/L即为血小板减少,常见于血小板生成障碍,如再生障碍性贫血,急性白血病,急性放射病等;血小板破坏增多,如原发性血小板减少性紫癜,脾功能亢进,戈谢病等,消耗过度如弥漫性血管内凝血,家族性血小板减少如巨大血小板综合征等。
2020年10月18日 21:03
ꄘ浏览量:0
版权声明:部分文章源于网络,如涉及版权,请联系删除!Email:3三49501801@qq.com
▶ 不一样的健康视角,不一样的健康获得!如果相同的方法不能获得相似的期望效果?那么,一定存在着相异的方法需要去发现…